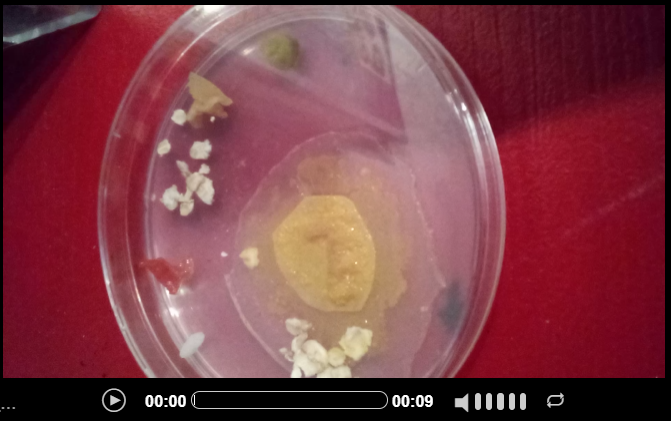

Les expérimentations de l’école de Peyrilles
A la découverte du blob
Voici la définition du Blob selon Samuel, élève de CM1 à Peyrilles
«Le blob est apparu il y a 1 milliard d’années. Il n’a pas de pattes mais pourtant il se déplace de 4 cm par heure. Le blob n’est ni une plante, ni un champignon et ni un animal. Son vrai nom est Physarum Polycephalum plus connu sous le nom de blob, surnom tiré d’un film d’horreur des années 50. Le blob habite dans les sous-bois et ressemble à un champignon».
Les élèves de l’école de Peyrilles ont commencé à l’étudier le 11 octobre 2021, ils participent à l’expérience #Elevetonblob proposée par le CNES (centre national des études spatiales) et le CNRS (centre national de la recherche scientifique). Ils ont été sélectionnés parmi les 4500 écoles participantes en France. Audrey Dussutour, biologiste chargée de la recherche au CNRS, est en contact avec les écoles pour les épauler et les aider à mener au mieux les expériences en classe. Quant à Thomas Pesquet, notre spationaute préféré, il a mené ses expériences en impesanteur, expériences que les élèves reproduiront sur Terre. Ils pourront ainsi comparer leurs résultats.
A l’école, les blobs sont arrivés sous la forme de sclérote, c’est-à-dire en état de dormance. Pour commencer à l’étudier, il faut le réveiller en le nourrissant de flocons d’avoine et en l’humidifiant de quelques goutes d’eau. Une fois réveillé, les élèves ont pu observer sa croissance et ont commencé à mener une expérience, celle du nom de « la cafétéria.» Pour cette expérience, il faut créer des menus pour le blob (4-5 aliments maximum) et constater ses préférences. Les enfants sont donc entrés dans la réelle démarche scientifique. Ils ont émis des hypothèses, fait l’expérience et l’ont filmée à l’aide de tablettes et le lendemain, ils ont interprété le petit film et ont rédigé une conclusion. La précision est de rigueur, les élèves manipulent le blob à l’aide d’outils de laboratoire (boites de pétri, pinces, pipettes), ce dernier dort dans sa blob box (boite) car il ne doit être en aucun cas en contact avec la lumière du soleil, cette dernière le tuerait.
Vous trouverez un timelapse de l’expérience « la cafétéria» menée par un groupe d’élèves en classe sur le Blob nommé «Blopuce».
Menu proposé (lecture dans le sens des aiguilles d’une montre) : Flocon d’avoine – Riz – Tomate – Pomme – Cornichon
Ici, les élèves ont conclu qu’il avait tout aimé sauf la tomate, aliment sur lequel il ne se trouve pas. Le blob est fascinant ! Chaque jour, les élèves l’observent et remplissent leur livret de « blobologiste » leur permettant de suivre l’évolution de leurs expériences. Pour ces vacances, les blobs ont été remis à l’état de dormance, il faut bien qu’ils puissent se reposer mais nous ne manquerons pas de donner des nouvelles à la rentrée, de nombreuses expériences sont prévues pour en apprendre davantage sur cette étrange créature.
La vidéo du blob faite à l’école

Quelle est l’origine de nos aliments? Visite de la ferme de Monsieur Bladié

L’origine de nos aliments étape 1: le lait.
Le mardi 19 octobre, après presque deux ans, les élèves de Concorès et Peyrilles repartent à la recherche de l’origine de leurs aliments avec cette fois comme première étape : l’origine des produits laitiers. C’est alors qu’ils se sont rendus à pied au lieu dit les Cabrayries, à Peyrilles, où Yannick Bladié, agriculteur depuis l’âge de 22 ans, les attendait en compagnie de ses collègues Jocelyne et Rosine.
Madame Bladié, mère de Monsieur Bladié, nous confiait : «Autrefois, avec mon mari, il y a 50 ans, nous avons commencé l’élevage avec seulement 4 vaches. Actuellement, nous en élevons 250, tout âge confondu. » Monsieur Bladié élève uniquement des vaches laitières. Le métier d’agriculteur est un métier à multiples facettes. Travail de la terre, gestion administrative et comptable, conduite et réparation des équipements, élever et soigner les animaux font partie du quotidien de l’agriculteur. Au programme de cette journée, les élèves ont nourri les veaux, visité la ferme, goûté du lait au chocolat et de la tomme des Pyrénées fournis par la coopérative Sodiaal à Montauban et enfin, dégusté le lait cru des vaches des Cabrayries. Monsieur Bladié a su présenter son métier avec passion, si bien que certains élèves sont repartis avec l’idée de devenir agriculteur. Mission réussie ! Après avoir trouvé réponses à leurs questions, les élèves sont retournés, enchantés, dans leurs écoles respectives avec quelques petits cadeaux et des papilles gustatives comblées.

Agir en bon cycliste à Peyrilles
Le vendredi 22 octobre, Jean-Paul, Bernard, Gérard et Jean-François sont intervenus bénévolement à l’école de Peyrilles dans le cadre de « L’association MAIF prévention », association qui participe à la prévention des risques sur la route. Enseignants retraités et passionnés, ils se déplacent dans les écoles du département du Lot toute l’année pour proposer des activités en lien avec la prévention routière à pied ou à vélo. En ce dernier jour d’école avant les vacances scolaires de la Toussaint, les élèves de CM ont bénéficié de l’intervention « agir en bon cycliste », intervention comprenant un parcours de motricité ainsi qu’une activité autour de la sécurité à vélo. A la fin de l’intervention, les élèves se sont vu remettre, par l’association, une casquette ainsi qu’un bracelet réfléchissant, accessoires qui seront utiles pour la sortie à vélo prévue en fin d’année. Un grand merci à l’association et plus particulièrement aux animateurs !

Commentaires les plus récents